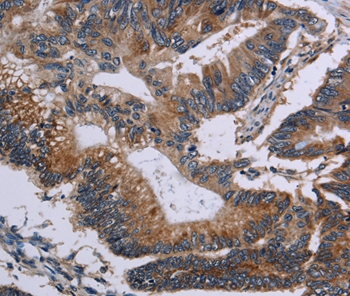
Anti-CLDND1 Antibody

Immunohistochemical staining of human cerebellum shows moderate cytoplasmic positivity in Purkinje cells.
Anti-CLDND1-25ul
HPA029841
ApplicationsWestern Blot, ImmunoCytoChemistry, ImmunoHistoChemistry
Product group Antibodies
ReactivityHuman
Overview
- SupplierAtlas Antibodies
- Product NameAnti-CLDND1-25ul
- Delivery Days Customer6
- ApplicationsWestern Blot, ImmunoCytoChemistry, ImmunoHistoChemistry
- Applications SupplierIHC, WB, ICC
- CertificationResearch Use Only
- ClonalityPolyclonal
- Concentration0.1
- ConjugateUnconjugated
- HostRabbit
- IsotypeIgG
- Protein IDQ9NY35
- Protein NameClaudin domain-containing protein 1
- Scientific DescriptionRabbit Polyclonal Anti-CLDND1 Antibody against Human claudin domain containing 1. Validated for Immunofluorescence, Immunohistochemistry and Western Blot
- ReactivityHuman
- Storage InstructionStore at +4°C for short term storage. Long time storage is recommended at -20°C.
- UNSPSC12352203